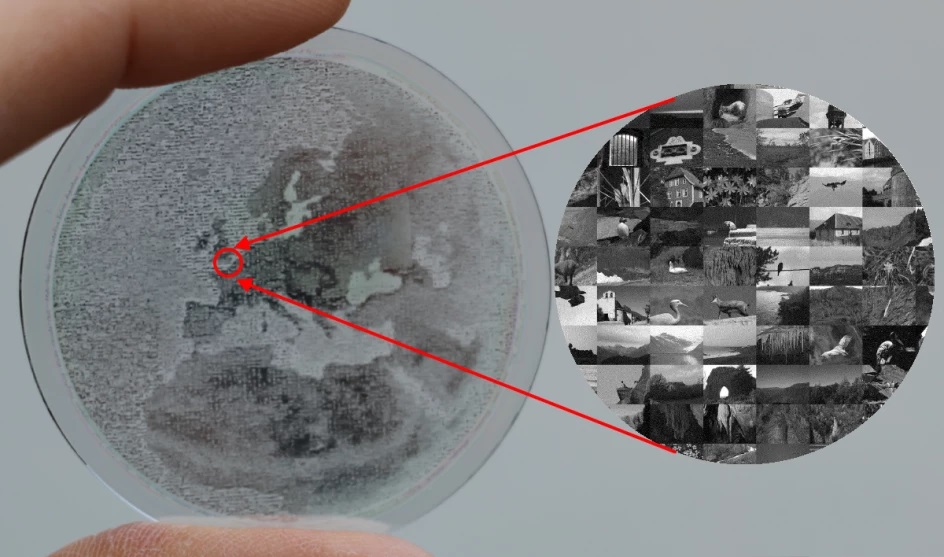

Le groupe EDM entre au capital de la start-up Arnano
Cette jeune pousse iséroise a développé une technologie permettant d’effectuer des microgravages sur saphir synthétique. Également isérois, EDM est un spécialiste de la transformation du métal à plat.
Le groupe EDM a annoncé avoir pris une participation au capital de la société Arnano, qui développe ses activités sur la base de technologies permettant d’effectuer de la microgravure. Cette entreprise créée en 2009, spin-off du CEA-Leti de Grenoble, propose diverses typologies d’applications dont des éléments décoratifs haut de gamme, supports d’archivage numériques, étiquettes pour la traçabilité, l’identification et la lutte contre la contrefaçon, ou encore des composants pour des Microsystèmes Opto-Électro-Mécaniques (MOEMS).
Gravage microscopique sur un saphir synthétique réalisé par la start-up Arnano.
Utilisant des technologies issues de la microélectronique, Arnano s’est fait une spécialité de la gravure à l’échelle microscopique. Située à Moirans (Isère), elle réalise notamment des composants fonctionnant sur le même principe que les puces électroniques. Arnano grave des films métalliques à base d’aluminium, or, chrome, alliage de chrome et nitrure de titane, qui sont déposés sur un substrat (verre, saphir, silicium, nacre, etc.), et peut aussi graver directement le substrat qui peut être multicouches.
Diversifier l’offre du groupe EDM
Pour Eric Marciano, président d’EDM, également implanté en Isère, à Saint-Jean-de-Moirans, cet investissement permettra de diversifier l’offre de ce groupe industriel spécialisé dans la transformation de métal à plat. EDM maîtrise plusieurs technologies à travers ses trois filiales : EDM Sodusi (Isère), DEP Industrie (Isère) et Chimic Métal (Val-de-Marne). Cela va de l’emboutissage, la découpe (mécanique et au laser) à la gravure chimique, et la soudure.